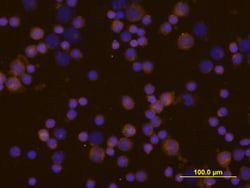
Img

AF18095
157252-30-7 | 5-Isoquinolinecarboxylicacid,8-amino-,methylester(9CI)
Manufacturer: A2B Chem
CAS Number: 157252-30-7
Select a Size
| Pack Size | SKU | Availability | Price |
|---|---|---|---|
| 50mg | AF18095-50mg | In Stock | ₹ 35,422.00 |
| 100mg | AF18095-100mg | In Stock | ₹ 50,374.00 |
| 250mg | AF18095-250mg | In Stock | ₹ 69,954.00 |
| 500mg | AF18095-500mg | In Stock | ₹ 1,07,245.00 |
| 1g | AF18095-1g | In Stock | ₹ 1,36,170.00 |
| 2.5g | AF18095-2.5g | In Stock | ₹ 2,62,105.00 |
| 5g | AF18095-5g | In Stock | ₹ 3,85,192.00 |
AF18095 - 50mg
In Stock
Quantity
1
Base Price: ₹ 35,422.00
GST (18%): ₹ 6,375.96
Total Price: ₹ 41,797.96
Catalog Number
AF18095
Chemical Name
5-Isoquinolinecarboxylicacid,8-amino-,methylester(9CI)
Cas Number
157252-30-7
Molecular Formula
C11H10N2O2
Molecular Weight
202.2093
Mdl Number
MFCD22376756
Smiles
COC(=O)c1ccc(c2c1ccnc2)N
Other Options
| Image | Product Name | Manufacturer | Price Range | |
|---|---|---|---|---|
 | 5-Isoquinolinecarboxylicacid,8-amino-,methylester(9CI) | Aaron Chemicals LLC | ₹ 26,967.00 - ₹ 3,11,233.00 | |
 | Methyl 8-aminoisoquinoline-5-carboxylate | ChemScene | -- |